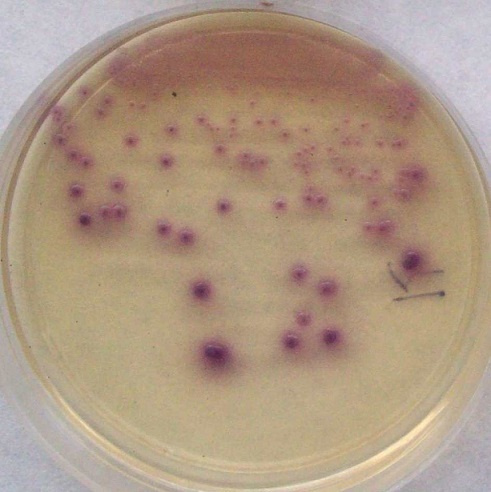

La estudiante de la Facultad de Medicina de la Universidad Nacional del Nordeste (UNNE) Jazmín Berecoechea, obtuvo una beca de Pregrado otorgada por la Secretaría General de Ciencia y Técnica de la institución, para obtener nuevos conocimientos sobre uno de los problemas para la salud en todo el mundo: la resistencia antimicrobiana (RAM).
La investigación que llevará adelante la becaria se denomina "Estudio de la susceptibilidad frente a antimicrobianos de uso en salud humana en aislamientos de Escherichia coli recuperados de diferentes especies animales".
El trabajo tendrá la guía y asesoramiento del doctor Luis Merino, quien además de ser el actual director del Instituto de Medicina Regional de la UNNE, es docente en la Cátedra de Microbiología, Parasitología e Inmunología de la Facultad de Medicina de la UNNE.

Según estimaciones de la Organización Mundial de la Salud (OMS), si no se toman medidas urgentes, para el año 2050 la resistencia antimicrobiana podría convertirse en la primera causa de muerte en el mundo, superando incluso al cáncer, con aproximadamente 10 millones de fallecimientos anuales.
La investigación se enmarca dentro del enfoque "Una Salud", que busca abordar de manera integral la relación entre ambiente, personas y animales, especialmente en lo relacionado a la vigilancia y combate de la multirresistencia bacteriana.
"Numerosas evidencias sugieren que los animales constituyen reservorios y vehículos ideales para la diseminación de la resistencia antimicrobiana", señaló Berecoechea. La transmisión entre animales y seres humanos puede producirse tanto por contacto directo como a través del ambiente contaminado con heces.
Un factor clave en la aparición de bacterias resistentes a antimicrobianos de última línea en animales es el uso indiscriminado de estos fármacos en la clínica veterinaria y como promotores de crecimiento en animales de cría.
El trabajo de Berecoechea tendrá relevancia ante "la falta de datos acerca de la presencia de aislamientos de Escherichia coli resistentes a antimicrobianos de uso en salud humana provenientes de animales en nuestra región", según destacó el Dr. Merino.
La investigación forma parte de un proyecto más amplio que busca detectar aislamientos resistentes en diversas especies animales para encontrar características distintivas entre los provenientes de diferentes orígenes, así como identificar los mecanismos que median las resistencias observadas.
Como parte de su trabajo, la becaria aislará Escherichia coli a partir de muestras de animales, determinará los perfiles de sensibilidad/resistencia frente a antimicrobianos de uso en medicina humana y comparará la actividad de los antibióticos estudiados entre las diferentes especies involucradas.
La hipótesis de trabajo, basada en la literatura consultada, es que "los aislamientos de Escherichia coli recuperados de diferentes especies animales presentan una resistencia menor al 10% frente a antimicrobianos, sin que se evidencien diferencias entre las especies de la cual provienen".
La investigación pretende generar conocimiento sobre la presencia de bacterias resistentes en animales de diferentes especies y su contribución a la diseminación de la resistencia antimicrobiana en el marco de "Una Salud".
La caracterización de la sensibilidad/resistencia antimicrobiana de las cepas permitirá comprender aspectos epidemiológicos de este creciente problema para la salud humana. Los resultados serán de gran utilidad para médicos y veterinarios que se enfrentan al desafío cotidiano de tratar infecciones por bacterias resistentes a tres o más familias de antimicrobianos.
Está previsto que los hallazgos se divulguen a través de presentaciones en eventos científicos y publicaciones en revistas especializadas, contribuyendo así al conocimiento colectivo sobre esta problemática sanitaria global.